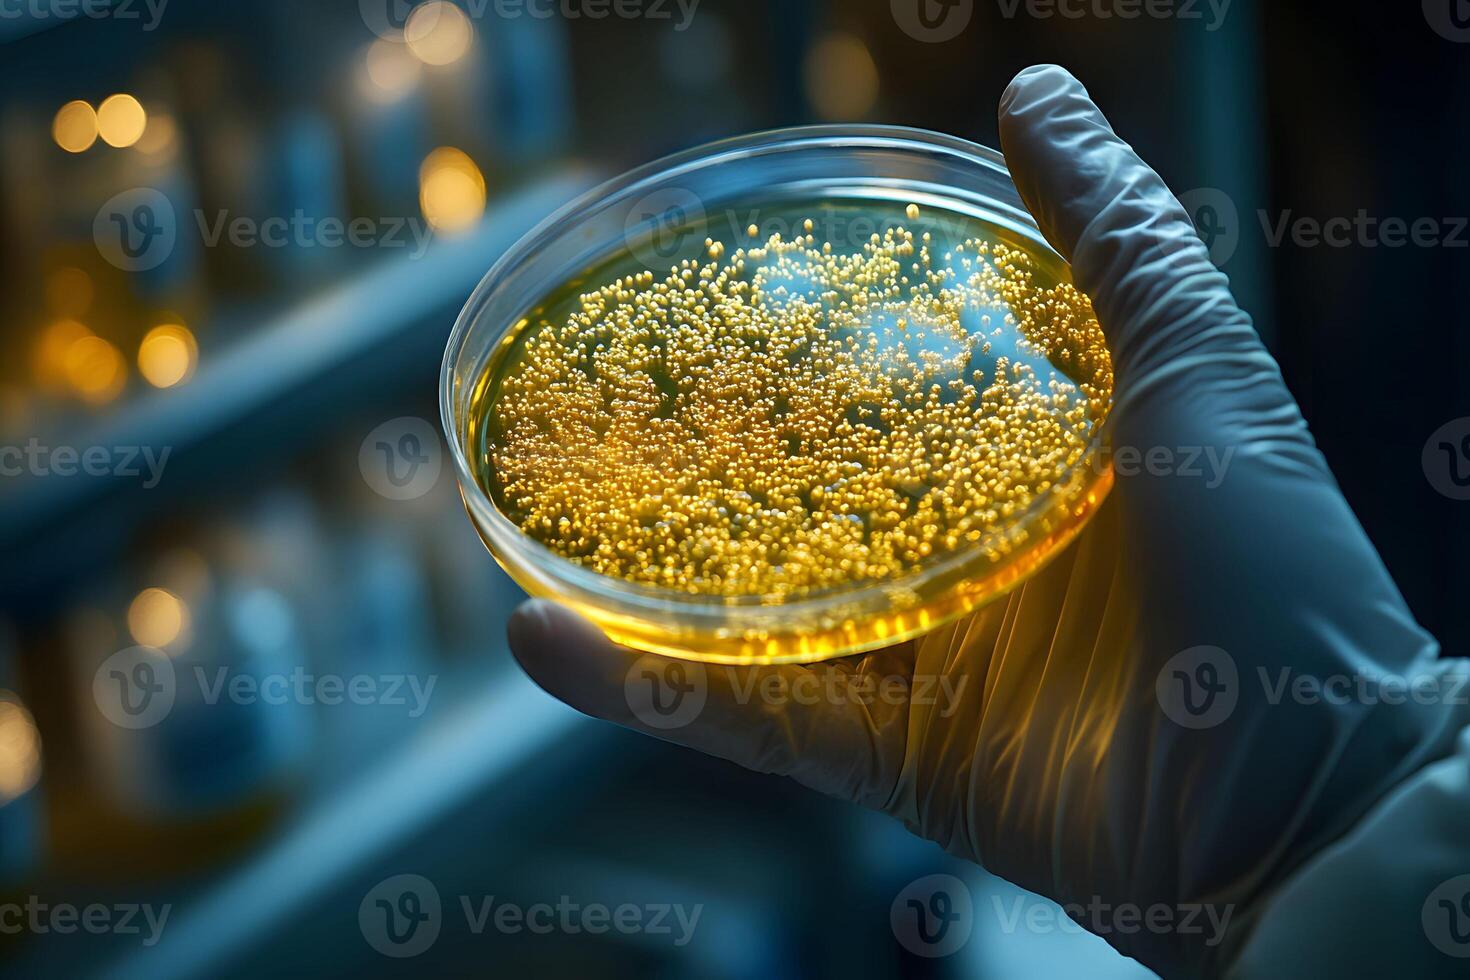

Vectores
Fotos
Vídeos
Editorial
Más


 Mis Colecciones
Mis Colecciones
Búsquedas de tendencias
Principales búsquedasBúsquedas de tendencias
Principales búsquedasBúsquedas de tendencias
Principales búsquedas


Vectores
Principales búsquedas
Páginas de vectores
Fotos
Principales búsquedas
Páginas de fotos
Videos